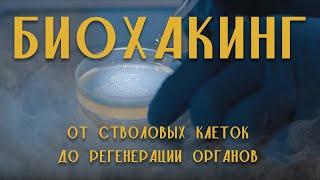

Комментарии:
Биохакинг: от стволовых клеток до регенерации органов
Sasha Kruasanova PROIT
Critical Ecosystem Restoration in the High Andes | The Ecopreneurs Ep 3 | Acción Andina
Global Forest Generation
Peak Performance | Helium Never Lets You Down
Peak Performance
World's Youngest Options Trader | Option Trading | 36% to 48% Returns | The Vivek Bindra Show
Dr. Vivek Bindra: Motivational Speaker
Episode 47: No Bake Cherry Cheesecake (Requested Recipe)
Ellen's Homemade Delights
Wolfbane's Lucky 13 Elixir review for June, 2016 Joe of all vapes.
Joe of all vapes😗💨
TIPOS DE PERONAS EN EL CARNAVAL
Ale Pinedo Tv